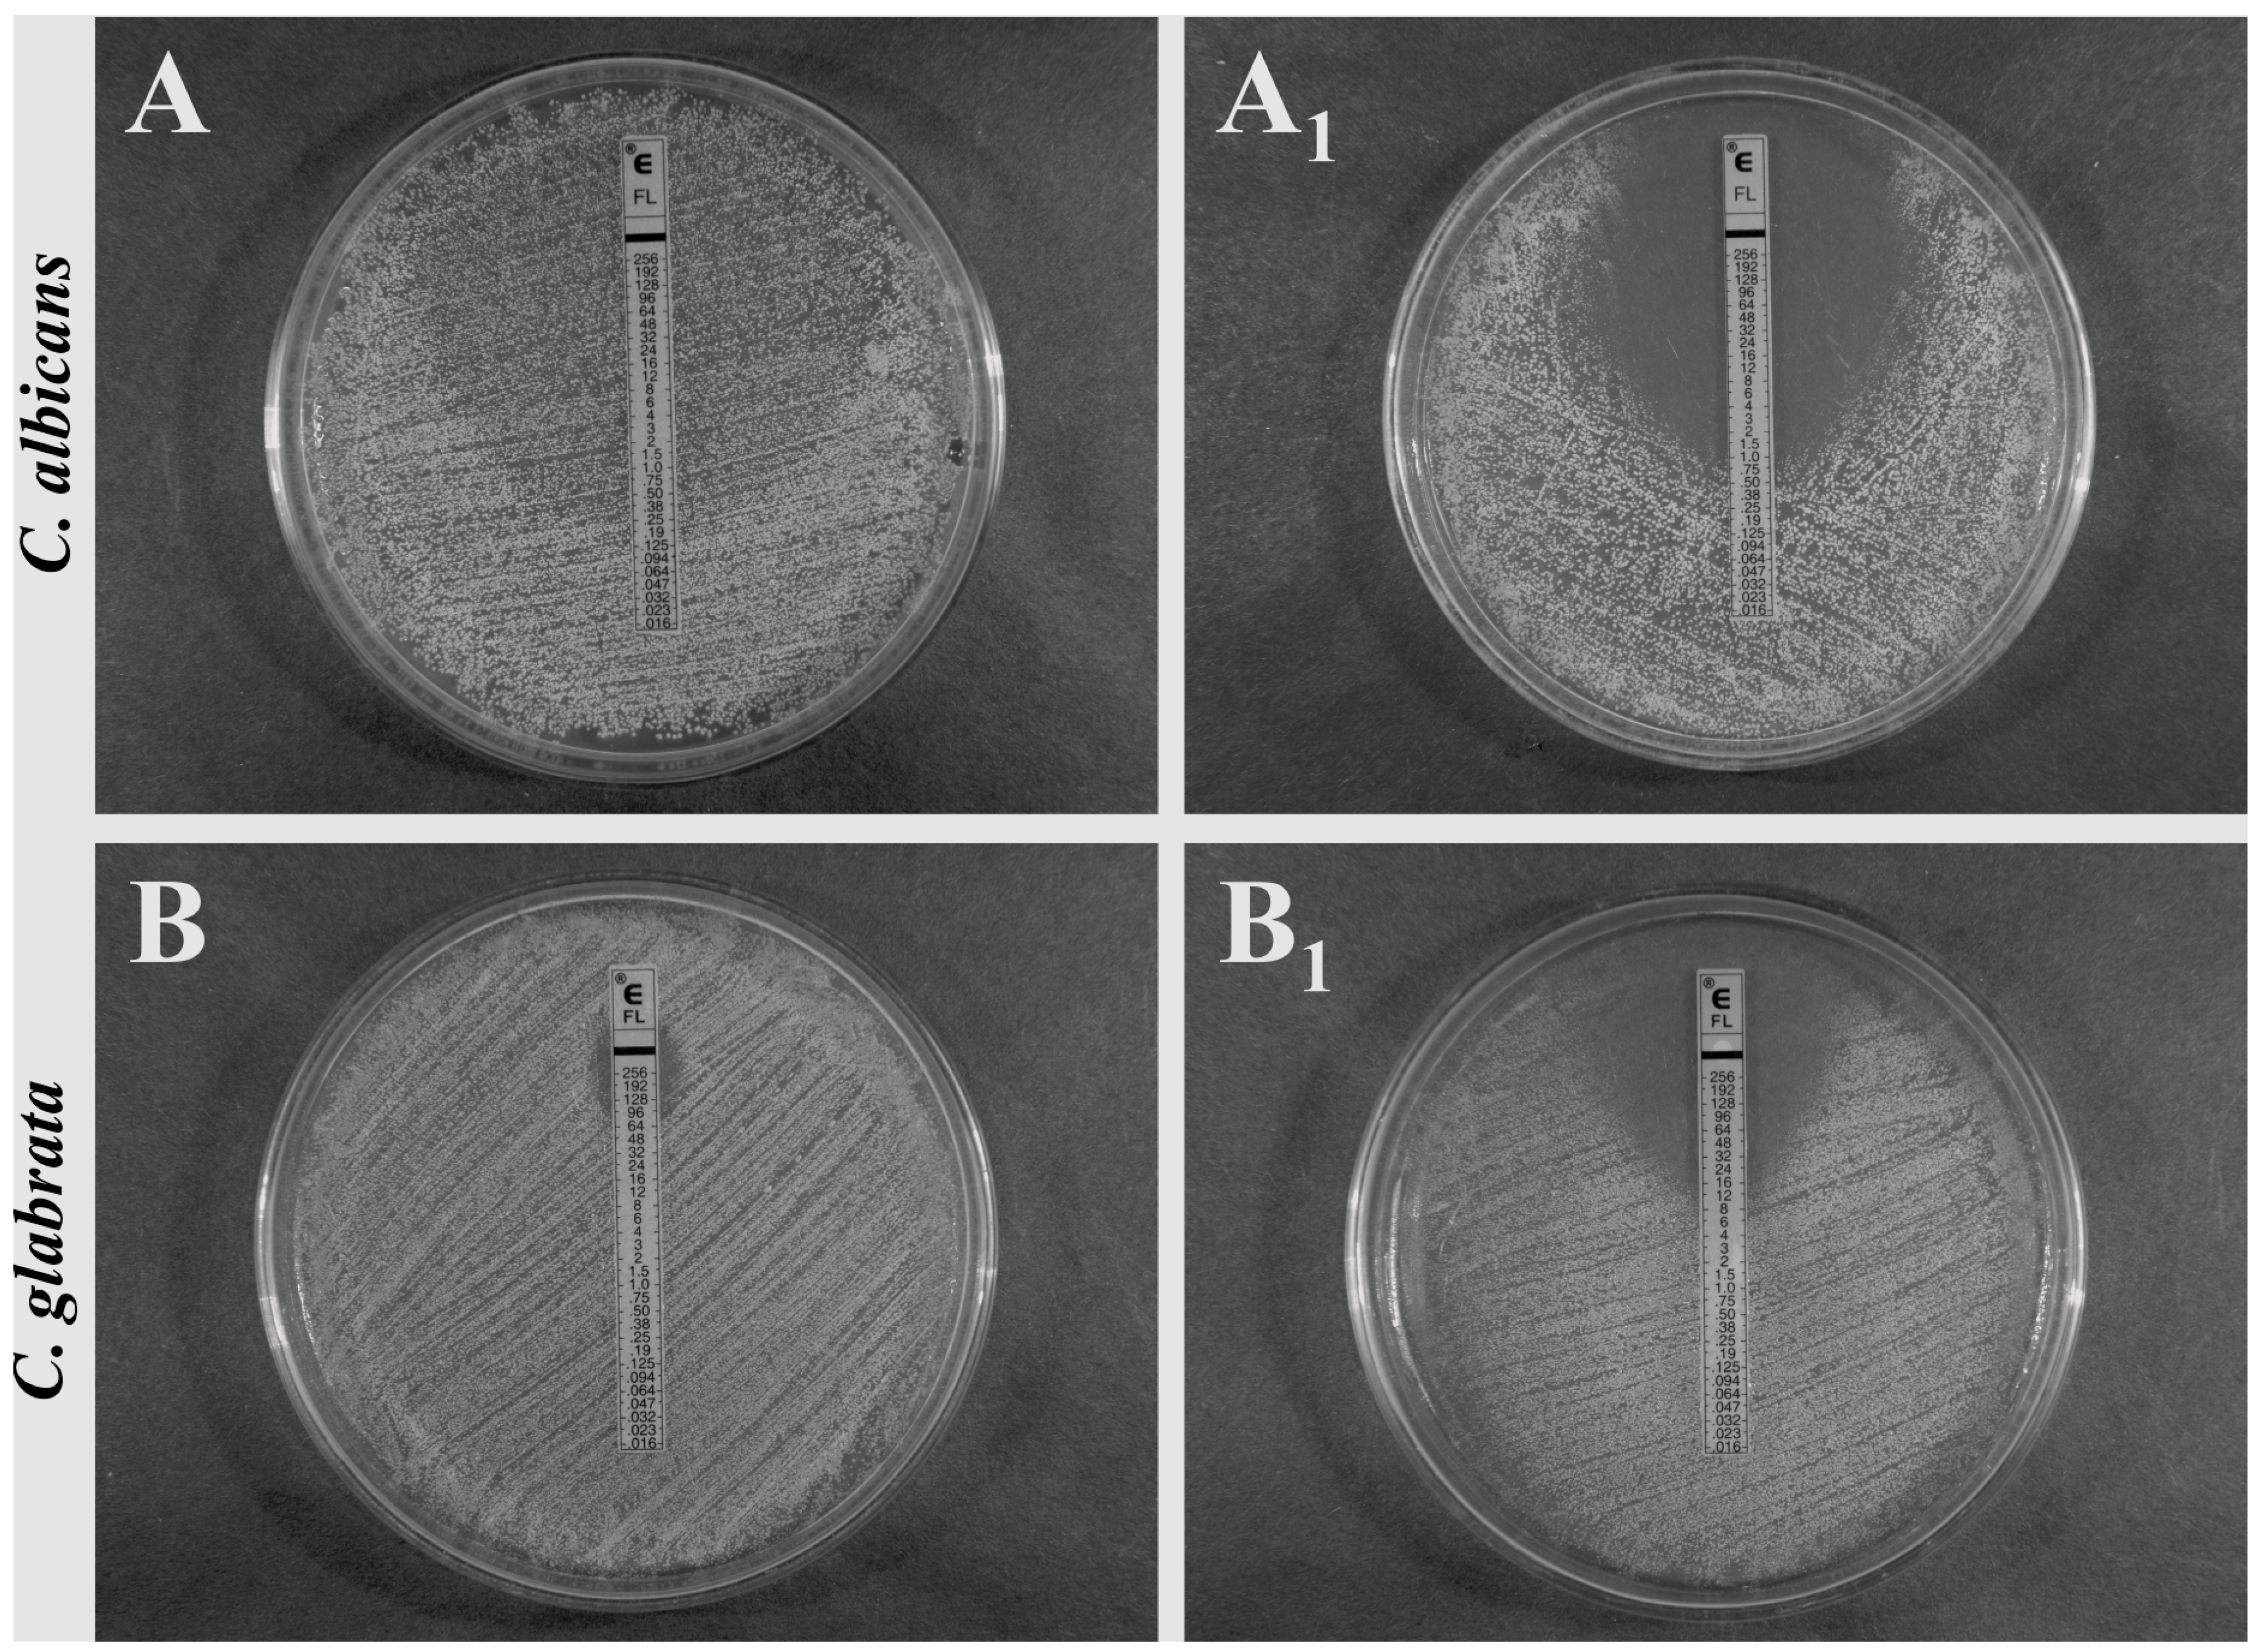

2. Results and Discussion
Research into new treatment options effective in combating infections involves a search for substances with different types of activity. They may have not only direct antimicrobial activity or exhibit a synergistic effect with conventional pharmaceutics, but also reduce the expression of pathogen virulence factors or activate host defense mechanisms [
3,
7,
8,
12]. The saponin fractions (SAPFs), obtained for the first time from the aerial parts of
T. alexandrinum,
T. incarnatum,
T. resupinatum var.
resupinatum, fulfill most of the above expectations. Our studies have showed novel pharmacological properties of these saponins, documenting their influence on more than usually tested pathogenesis attributes relevant for
Candida patomechanisms [
11,
13]. The analysis of
Trifolium extract fractions by HPLC-ELSD revealed their total saponin content in relation to all presented peaks, and amounted to 79.92%, 97.83% and 90.21% of saponins for
T. alexandrinum,
T. incarnatum, and
T. resupinatum var.
resupinatum, respectively. The tentative identification of the major components of each fraction was carried out through a careful study of their ESI-MS/MS fragmentation pattern and comparison with the pre-existing literature data. Two triterpenoid glycosides,
i.e., soyasaponin Bb (soyasaponin I) and soyasaponin βb (soyasaponin I conjugated at the 22-position with DDMP), previously characterized in the seeds of several clovers, were found as a major saponins in three tested species [
14]. The SAPF of
T. alexandrinum contained mainly these two compounds, which represented 85.95% and 5.91% of total saponins for soyasaponin Bb and βb, respectively. The chromatogram of crimson clover fraction also composed principally of two aforementioned triterpenoid glycosides, but in different amount ratio as compared to the previous fraction. Thus, the main saponins of the SAPF of
T. incarnatum were soyasaponin βb (48.19% of total saponins) and soyasaponin Bb (43.46% of total saponins). The composition of saponin fraction of
T. resupinatum var.
resupinatum was the most complex among tested fractions, and consisted of several peaks from which major three were identified as soyasaponin Bb, Bb’(soyasaponin III) and βb [
14]. Their quantitative ratio was as follows, 45.75%, 15.03% and 12.36% of total saponins for soyasaponin Bb, Bb’ and βb, respectively.
According to above analysis the saponin fraction of
T. alexandriunum contained the residues of flavonoids (apigenin and its glucosides), that amounted to 15.20% of total peaks presented in the chromatogram. However, the final concentration of apigenin and derivatives in the sample used in our experiments was far too low to cause the observed biological effects. For example, in the publication by Cheah
et al. [
15], the minimal concentration of apigenin inhibiting growth of
C. albicans was rated at 125 µg/mL, while in the saponin—rich fraction obtained from the extract
T. alexandrinum its concentration could reach 8 times lower level (a maximum concentration of only about 18 µg/mL). Even taking into account the synergistic effect of the ingredients of plant extract, it is unlikely that such a concentration of apigenin could affect the final outcome of its antifungal action. This conviction is supported by data from the literature, as well as by own experience of the subject. Additionally, the experimental data on the viability and function of mammalian cells influenced by apigenin indicate that this flavonoid at a 25–40 µM concentration affected cell growth and was cytotoxic [
16,
17]. Thus, if present in our product apigenin (not saponins) showed activity, this should occur during the assessment of cytotoxicity of SAPF and it did not happen. According to the results of an MTT- reduction test with L929 fibroblasts, none of the saponin fractions, used at the concentrations range of 0.003–0.5 mg/mL, did not reduce vital cell numbers (
p > 0.05) after 0.5 h of incubation (data not shown). Values of IC
50 after 24 h of co-incubation were as follows: for
T. alexandrinum—0.125 mg/mL; for
T. resupinatum and
T. incarnatum—0.25 mg/mL. Moreover, these SAPFs showed no hemolytic activity on TSA/5% of human erythrocytes, while the diameter of the zones of hemolysis induced by standard saponin—Quil A (from
Quillaja saponaria) were, respectively, 3.0 ± 0.67 mm for 0.25 mg/mL, 3.94 ± 0.5 mm for 0.5 mg/mL, and induced by Triton 1% X-100 (positive control)—9.33 ± 0.94 mm. Thus, the antifungal effects of saponins observed in further studies were caused by them, but not by additional components.
Minimal fungistatic concentrations of SAPFs against C. albicans ATCC 10231 and C. glabrata clinical isolate exceeded the concentration of 1 mg/mL (w/v). Based on this, the concentrations of 0.125, 0.25 and 0.5 mg/mL, which did not cause yeast growth inhibition, were arbitrarily considered as subMICs of the SAPFs and were further interchangeably used.
The first question that we asked, is it efficient oxidative stress response of
Candida will be affected by saponin action. Such a response may be of clinical interest, since it is important for
C. albicans invasion and colonization of host tissues and survival within the host cells (phagocytes) in the course of an
in vivo infection [
18,
19]. It is known that
C. albicans strains show
in vitro a high natural resistance to H
2O
2 and various protocols of treatment with this agent (concentration- and time-dependent) have distinct effects on antioxidant enzymes (catalase, superoxide dismutase, glutathione oxidase) expression [
18]. In our study,
C. albicans ATCC 10231 cells when exposed to SAPFs (0.5 mg/mL), exhibited lower oxidative stress tolerance after their treatment with various doses of hydrogen peroxide than the control cells. The most significant increase in susceptibility to oxidative stressor was caused by
T. alexandrinum—derived saponins (
Figure 1). Spot plating of the pre-exposed yeasts on media containing different concentrations of the cell wall damaging agent—Calcofluor White, or media containing NaCl as osmotic stress factor, resulted in a reduction of visible growth intensity and delay of the growth time. However, the last two effects were not statistically significant (data not shown). In this part of the study our results have shown that saponins may cause changes in the composition of the cell wall of
Candida, since its sensitivity not only to hydrogen peroxide but also slightly to Calcofluor White, have increased. It has been reported that Calcofluor binds to β-linked fibrillar polymers, interferes with chitin assembly resulting in growth rate reduction, and alters incorporation of mannoproteins into cell wall. Therefore, it cannot be ruled out that the architecture of the cell wall proteome might be changed by possibly preventing correct positioning and anchoring of cell wall localized superoxide dismutase or other proteins that are directly or indirectly responsible for countering stress damage [
20,
21]. Indirect evidence for the change in cell wall permeability of
Candida caused by the action of saponin was delivered in experiment, wherein the yeast after a 2 h pre-incubation were stained with propidium iodide, and observation of cell morphology was made under a microscope. The results are shown in
Figure 2.
Figure 1.
The oxidative stress tolerance assay of C. albicans ATCC 10231 pre-cultured for 24 h at 35 °C on control SDA (
A) or on SDA +
T. alexandrinum SAPF (0.5 mg/mL); (
B) The inocula of yeasts prepared in this way, were further incubated with different concentrations of hydrogen peroxide for 1 h at room temperature, diluted (10
5 to 10
3 cells/mL) and spotted (5 μL) on YPG plates. Intensity of growth (micro- and macrocolony morphology) was evaluated after the following 48 h of incubation at 30 °C. Four independent experiments were performed. In
Figure 1, the representative data are shown.
Figure 1.
The oxidative stress tolerance assay of C. albicans ATCC 10231 pre-cultured for 24 h at 35 °C on control SDA (
A) or on SDA +
T. alexandrinum SAPF (0.5 mg/mL); (
B) The inocula of yeasts prepared in this way, were further incubated with different concentrations of hydrogen peroxide for 1 h at room temperature, diluted (10
5 to 10
3 cells/mL) and spotted (5 μL) on YPG plates. Intensity of growth (micro- and macrocolony morphology) was evaluated after the following 48 h of incubation at 30 °C. Four independent experiments were performed. In
Figure 1, the representative data are shown.
Figure 2.
C. albicans control and T. alexandrinum SAPF—treated cells (at concentration of 0.125, 0.25 mg/mL) stained after 0 and 2 h of co-incubation with propidium iodide (60 µM). Undamaged cells (gray/transparent) and the cells with impaired cell wall permeability (red) were determined using a Confocal Laser Scanning Microscope (PI fluorescence detected at the excitation of 543 nm). The presented images are representative from two independent experiments.
Figure 2.
C. albicans control and T. alexandrinum SAPF—treated cells (at concentration of 0.125, 0.25 mg/mL) stained after 0 and 2 h of co-incubation with propidium iodide (60 µM). Undamaged cells (gray/transparent) and the cells with impaired cell wall permeability (red) were determined using a Confocal Laser Scanning Microscope (PI fluorescence detected at the excitation of 543 nm). The presented images are representative from two independent experiments.
Very important and well known virulence factors of
Candida cells are hydrolytic enzymes such as proteases, lipases and phospholipases, playing a role in nutrition, adhesion to host cells, and tissue destruction. The most important are Sap (secreted aspartyl proteinases)—Sap 1–3 are secreted by blastospores, Sap 4–6 are released mainly by filamentous forms, and Sap 9 and 10 are strongly associated with the cell wall of both morphotypes. Protease activity is complemented by the action of phospholipases, which are enzymes responsible for the hydrolysis of one or more ester bonds in the cell membrane glycerophospholipids. Among the seven known types of
C. albicans secreted phospholipases, the most important seems to be a phospholipase B, which causes the release of fatty acids from phospholipids and lysophospholipids, playing an important role in the penetration of host tissues [
2,
19,
22]. Our second goal, justified by the above information, was to test enzymatic activity of yeasts pretreated with saponins. Using a semi-quantitative API ZYM test, it was demonstrated that
C. albicans reference ATCC 10231 strain exhibited the activity of 9/19 hydrolytic enzymes,
i.e., alkaline phosphatase, esterase (C4), esterase lipase (C8), leucine and valine arylamidase, acid phosphatase, naphthol-AS-BI-phosphohydrolase, α-glucosidase, and N-acetyl-β-glucosaminidase. Treatment of this strain with SAPFs (at 0.5 mg/mL) revealed a statistically significant decrease in the release of some of the enzymes, including acid and alkaline phosphatase, naphthyl-AS-BI-phosphohydrolase and
N-acetyl-β-glucosaminidase. The production of other enzymes was also slightly affected (
Table 1). The observation that enzymatic activity of
Candida treated with SAPFs was significantly decreased is important in the light of the results of other experiments on the formation of filaments. In the constant presence of SAPFs at 0.25 mg/mL in RPMI-FCS medium, germ tubes (GT) formation by
C. albicans ATCC 10231 strain was significantly inhibited (
Figure 3B). The number of GT-positive cells per 100 cells, evaluated after 3 h of co-incubation, dropped from 18.6 ± 1.4 to app. 9.2 ± 1.75 − 10.9 ± 0.4. The mean percentage of GT reduction caused by the individual SAPF only slightly differed (42%–54%) indicating that all SAPFs were equally potent in this respect. Interestingly, the observed reduction in
C. albicans ability to form filaments was irreversible, as verified during prolonged incubation of preincubated yeasts, for a total of 24–48 h. During this time
C. albicans control cells formed aggregates (microcolonies) interspersed with filaments and true hyphae (mycelium) (
Figure 3A,A
1), while yeasts treated earlier with subMIC of SAPFs had a form of short blastospore-budding chains (
Figure 3B,B
1).
Table 1.
API ZYM test for C. albicans ATCC 10231 enzymatic activity under the influence of Trifolium spp—derived SAPFs. The mode of phytocompounds action, used at subMICs (0.5 mg/mL) was as described in the Experimental section.
Table 1.
API ZYM test for C. albicans ATCC 10231 enzymatic activity under the influence of Trifolium spp—derived SAPFs. The mode of phytocompounds action, used at subMICs (0.5 mg/mL) was as described in the Experimental section.
| SAPFs | Hydrolytic Enzymes * Activity [nmol] |
|---|
| E2 | E3 | E4 | E6 | E7 | E11 | E12 | E16 | E18 |
|---|
| Control (−) | 10 | 30 | 20 | 30 | 10 | 40 | 30 | 20 | 30 |
| T. alexandrinum | 0 | 20 | 20 | 20 | 10 | 0 | 10 | 30 | 0 |
| T. incarnatum | 0 | 30 | 10 | 30 | 10 | 10 | 10 | 30 | 10 |
| T. resupinatum | 0 | 30 | 20 | 30 | 10 | 20 | 20 | 20 | 20 |
Figure 3.
Kinetics of C. albicans ATCC 10231 germ tube formation after 1, 2, 3 h of incubation in RPMI-FCS medium in the presence of T. alexandrinum SAPF (A)—0.125 mg/mL or (B)—0.25 mg/mL. The results are expressed as mean GFT/100 cells ± S.D., evaluated at each time point. T. a.—Trifolium alexandrinum; T. i.—T. incarnatum; T. r—T. resupinatum.
Figure 3.
Kinetics of C. albicans ATCC 10231 germ tube formation after 1, 2, 3 h of incubation in RPMI-FCS medium in the presence of T. alexandrinum SAPF (A)—0.125 mg/mL or (B)—0.25 mg/mL. The results are expressed as mean GFT/100 cells ± S.D., evaluated at each time point. T. a.—Trifolium alexandrinum; T. i.—T. incarnatum; T. r—T. resupinatum.
This effect was correlated with the reduction in the invasive capacity of the yeasts, as stated in the standard test simulating their penetration into tissues. Filaments (hyphal growth examined using a stereomicroscope), seen at the edges of
Candida colonies grown in the control were large and formed an extensive spider branched zone around a dense mass of mycelium, while
C. albicans spotted on the Spider agar containing individual SAPF (0.25 mg/mL) were unable to penetrate this medium. The effect of SAPFs used at a lower concentration (0.125 mg/mL) was weaker, however, also noticeable. An example result of
T. alexandrinum SAPF activity is shown in
Figure 4A
2,B
2,C
2 (right column).
It is assumed that the most enzymatically active parts are apical tips of young hyphal cells which are best suited to adhere to and invade host tissues. Yeast treated earlier with subMIC of SAPFs took at the tested end-points a form of short blastospore-budding chains. It is an important achievement, since young buds might be more susceptible to antifungals and,
in vivo, to the activity of host immune effector mechanisms. These results suggest that the morphological transformation of
C. albicans cells under the influence of SAPFs is completely blocked. At this stage of the study, however, we do not know what the precise mechanism of their action is. According to Biswas
et al. [
20] and Thompson
et al. [
21] and others [
2,
3,
19] filamentation is controlled by a very complex network of regulatory pathways that converge onto specific transcriptional regulators.
Figure 4.
Hyphae formation (left and middle columns) by C. albicans ATCC 10231 strain cultured in RPMI-FCS medium in the absence (A, A1) or presence of T. alexandrinum SAPF at concentration of 0.25 mg/mL (B, B1) or at concentration of 0.125 mg/mL (C, C1), tested after 24 h or after 48 h. At the indicated time points of culture, samples were withdrawn, evaluated microscopically (light microscope 400× magnification). Mycelium formation (right column) by C. albicans ATCC 10231 colonies grown for 7 days at 30 °C on (A2)—control Spider medium; (B2)—Spider medium + SAPF 0.25 mg/mL; (C2)—Spider medium + SAPF 0.125 mg/mL. The presence or lack of hyphal growth at the colony edges was determined using a stereomicroscope (12× magnification). The presented images are representative from two independent experiments.
Figure 4.
Hyphae formation (left and middle columns) by C. albicans ATCC 10231 strain cultured in RPMI-FCS medium in the absence (A, A1) or presence of T. alexandrinum SAPF at concentration of 0.25 mg/mL (B, B1) or at concentration of 0.125 mg/mL (C, C1), tested after 24 h or after 48 h. At the indicated time points of culture, samples were withdrawn, evaluated microscopically (light microscope 400× magnification). Mycelium formation (right column) by C. albicans ATCC 10231 colonies grown for 7 days at 30 °C on (A2)—control Spider medium; (B2)—Spider medium + SAPF 0.25 mg/mL; (C2)—Spider medium + SAPF 0.125 mg/mL. The presence or lack of hyphal growth at the colony edges was determined using a stereomicroscope (12× magnification). The presented images are representative from two independent experiments.
Anyway, the capacity of each compound to inhibit germ tube formation could be an important factor to assess its antifungal activity. The most important achievements involved reduced enzymatic activity of Candida, as increased sensitivity of their cells to oxidative stress, and impaired morphological transition, as well invasive properties. The yeast-to-hypha transformation has been shown to be one of the most important among several virulence attributes that enable C. albicans to invade human tissues.
Prepared saponins had no direct strong antifungal activity within the concentration range tested. However, when used at subMIC together with anti-mycotic drugs, they exhibited significant synergistic activity, mainly with drugs from the azole therapeutic group (
Table 2). The results from a disk-diffusion assay show that SAPFs (mixed with SDA medium), combined with azoles (miconazole, clotrimazole, ketoconazole, econazole containing disks) caused prominent effect. In contrast, amphothericin B, nystatin, natamycin and flucytosin combined with SAPFs had no, weak or insignificant synergistic mode of interactions.
Table 2.
Synergistic activity of Trifolium spp—derived SAPFs at subMIC with selected anti-mycotic chemotherapeutics. AmB—amphotericin B; KCA—ketoconazole; ECN—econazole; NY—nystatin; FY—flucytosin.
Table 2.
Synergistic activity of Trifolium spp—derived SAPFs at subMIC with selected anti-mycotic chemotherapeutics. AmB—amphotericin B; KCA—ketoconazole; ECN—econazole; NY—nystatin; FY—flucytosin.
| SAPFs | Anti-Mycotic Agent, Growth Inhibition Zone [mm ± S.D.] |
|---|
| AmB x | KCA x | KCA xx | ECN x | ECN xx | NY x | FY x |
|---|
| Control (−) | 12.0 ± 0 | 0 | 20.0 ± 0.0 | 11.0 ± 0.0 | 20.5 ± 0.5 | 18.0 ± 2.3 | 0 |
| T. alexandrinum | 11.0 ± 0 | 17.0 ± 0.0 | - | 14.0 ± 0.0 | - | 19.5 ± 0.7 | 0 |
| T. incarnatum | 11.0 ± 0.5 | 18.5 ± 0.7 | - | 14.5 ± 0.0 | - | 18.0 ± 0.0 | 0 |
| T. resupinatum | 10.5 ± 0.5 | 16.2 ± 0.9 | - | 12.0 ± 0.0 | - | 18.0 ± 0.5 | 0 |
The interesting effect of saponins in combination with some azoles is worth mentioning. The large zone of microcolonies around the disk with ketoconazole observed in the control (20 mm) disappeared under the influence of SAPFs subMIC, while previously absent zone of complete growth inhibition occurred. Its diameter was from 14.2 mm to 20.5 mm, depending on the SAPFs type. A similar effect was observed around the disk with econazole (
Table 2).
Since the disc diffusion method is only a semi-quantitative test, the extension of the study involved the evaluation of MIC value changing upon the SAPFs influence, using a strips of ellipsometric test (Etest), containing a representative triazole (fluconazole, FLC). Its MIC against
C. albicans ATCC 10231, measured according to the CLSI recommendation (80% growth inhibition), was 0.25 mg/L. In the case of yeasts treated with individual SAPFs, the end-point value as such did not change, while the zone with a lawn of microcolonies within a discernable ellipse disappeared and complete growth inhibition (100%) was observed (sharp end point of 0.75 mg/L could be noticed). The effect of
T. alexandrinum SAPF which was the most significant, is presented in
Figure 5A,A
1.
Most interestingly, when fluconazole-resistant
C. glabrata clinical strain (MIC FLC > 64 mg/L) was used for the same purpose, the effect of synergism was also seen. FLC MIC of
C. glabrata strain was decreased eightfold by the action of subMIC of SAPFs, from 64.0 mg/L to the level of 8.0 mg/L. Such evident effect was only observed while using
T. alexandrinum saponins (
Figure 5B,B
1). In other cases, the effect was noticeable but clearly weaker (data not shown).
Why are saponins so interesting in this respect? Firstly, these products are characterized by wide antimicrobial activity. Secondly, saponins differ in their chemical structure and characteristics showing also antioxidant, anti-inflammatory, and anti-apoptotic properties. In order to combat infection, their hydrophobic constituents contact directly the phospholipid bilayer of the microbial cell membrane, leading to an increase in the ion permeability, leakage of vital intracellular constituents or impairment of the pathogen enzyme systems and their respiration, as well as inhibition of protein synthesis and assembly. Their antifungal properties are also related to the ability of the main constituents to pass through the thick fungal cell wall and settle between fatty acid chains of lipid bilayers, disrupting lipid packaging and altering the structure of the cell membrane [
4,
5].
Figure 5.
Synergistic activity of T. alexandrinum SAPF (0.25 mg/mL) with fluconazole towards C. albicans ATCC 10231 and C. glabrata clinical strain, measured by the antibiotic gradient strip (E-test). The growth inhibition zones/MIC were measured after yeasts growth at 37 °C for 24–48 h on control medium: RPMI-1640 with 2% glucose (A,B) or on medium + SAPF (A1,B1). The test end-points were evaluated according to the manufacturer’s recommendations. The presented images are representative from two independent experiments.
Figure 5.
Synergistic activity of T. alexandrinum SAPF (0.25 mg/mL) with fluconazole towards C. albicans ATCC 10231 and C. glabrata clinical strain, measured by the antibiotic gradient strip (E-test). The growth inhibition zones/MIC were measured after yeasts growth at 37 °C for 24–48 h on control medium: RPMI-1640 with 2% glucose (A,B) or on medium + SAPF (A1,B1). The test end-points were evaluated according to the manufacturer’s recommendations. The presented images are representative from two independent experiments.
The latter property suggests that saponins can be used to support the activity of antifungal drugs targeting sterol compounds of the cytoplasmic membrane (polyenes, azoles). In the present study we have proved such a possibility. An interesting result of SAPFs combination with ketoconazole and econazole was shown. Their fungistatic action was replaced by a complete growth inhibition due to SAPFs presence in the medium. It is also a point of interest that synergistic interactions of SAPFs with representative triazole—fluconazole (FLC) against Candida strains with different susceptibility was obtained. Using a quantitative E-test, it was observed that subMIC of SAPFs made susceptible C. albicans more susceptible, and what is even more important, the resistance of C. glabrata strain decreased.
Our observation is that the level of resistance to fluconazole can be decreased by the action of SAPFs subMIC encourages further research in this area. Recently, fluconazole-resistant
C. albicans strains and intrinsically resistant
Candida species such as
C. glabrata have been emerging in immunocompromised patients treated with FLC for therapy or prophylaxis. Trying to explain the mechanism of synergistic action of saponins with fluconazole, we have to go back to the determinants of fungal resistance to this drug. The molecular basis of fluconazole resistance includes modifications in the
ERG11 gene encoding the main enzymes of ergosterol biosynthesis, overexpression of genes encoding efflux pumps, and others which have not been well defined yet [
23,
24]. Based on the results of the performed experiments, we cannot identify the exact mechanism responsible for the synergism of fluconazole and saponins. However, it can be tentatively suggested that it is due to the facilitated penetration of the drug into the cell, which is high enough that the membrane transporters are becoming less effective. This suggestion can be confirmed by the results indicating the absence of clear synergism between saponins and polyene anti-mycotics such as amphotericin B and nystatin. It is known that they are not substrates for efflux pumps [
25].
Considerations as to which of the examined clover species is the best source of saponins having the desired properties should be related to an analysis of their concentration, composition and, first of all, of course their impact on the tested attributes of
Candida. Oleszek and Stochmal [
9] studied the occurrence and concentration of soyasapogenol B glycosides in the seeds of 57 clover species, including
T. alexandrinum,
T. incarnatum,
T. pratense,
T. resupinatum var.
resupinatum and
T. resupinatum var.
majus Boiss. In the case of berseem clover, soyasaponin I and its 22-
O-diglucoside were quantified, and astragaloside VIII was also detected but in a very low amount, while soyasaponin Bb and its 22-
O-diglucoside were found in the crimson clover (
T. incarnatum). Similarly, soyasaponin I was the most abundant saponin in the Persian clover (
T. resupinatum) varieties.
It appears that saponin fraction of
T. alexandrinum (berseem clover), containing mainly soyasaponin Bb (85.95% of total saponins) and accompanying soyasaponin βb (5.91% of total saponins), cause the most significant effects. The SAPFs of
T. incarnatum and
T. resupinatum var.
resupinatum characterized by either similar saponin profile with different ratio of major compounds or different saponin profile, in relation to the previous one, were less active. Numerous studies have revealed that the distribution and composition of saponins in different organs and tissues of plants are dependent on the stage of ontogenesis and variable environmental factors [
9,
11,
26]. It is so important that the only standardized plant preparations, with a well-documented biological activity, have a chance to exist as a safe medical products, supporting the currently used therapeutics (a checkerboard assay is needed). Ensuring that objective is also justified by the new approach to combating infectious diseases, which is the use of immunomodulatory activity of phytochemicals.